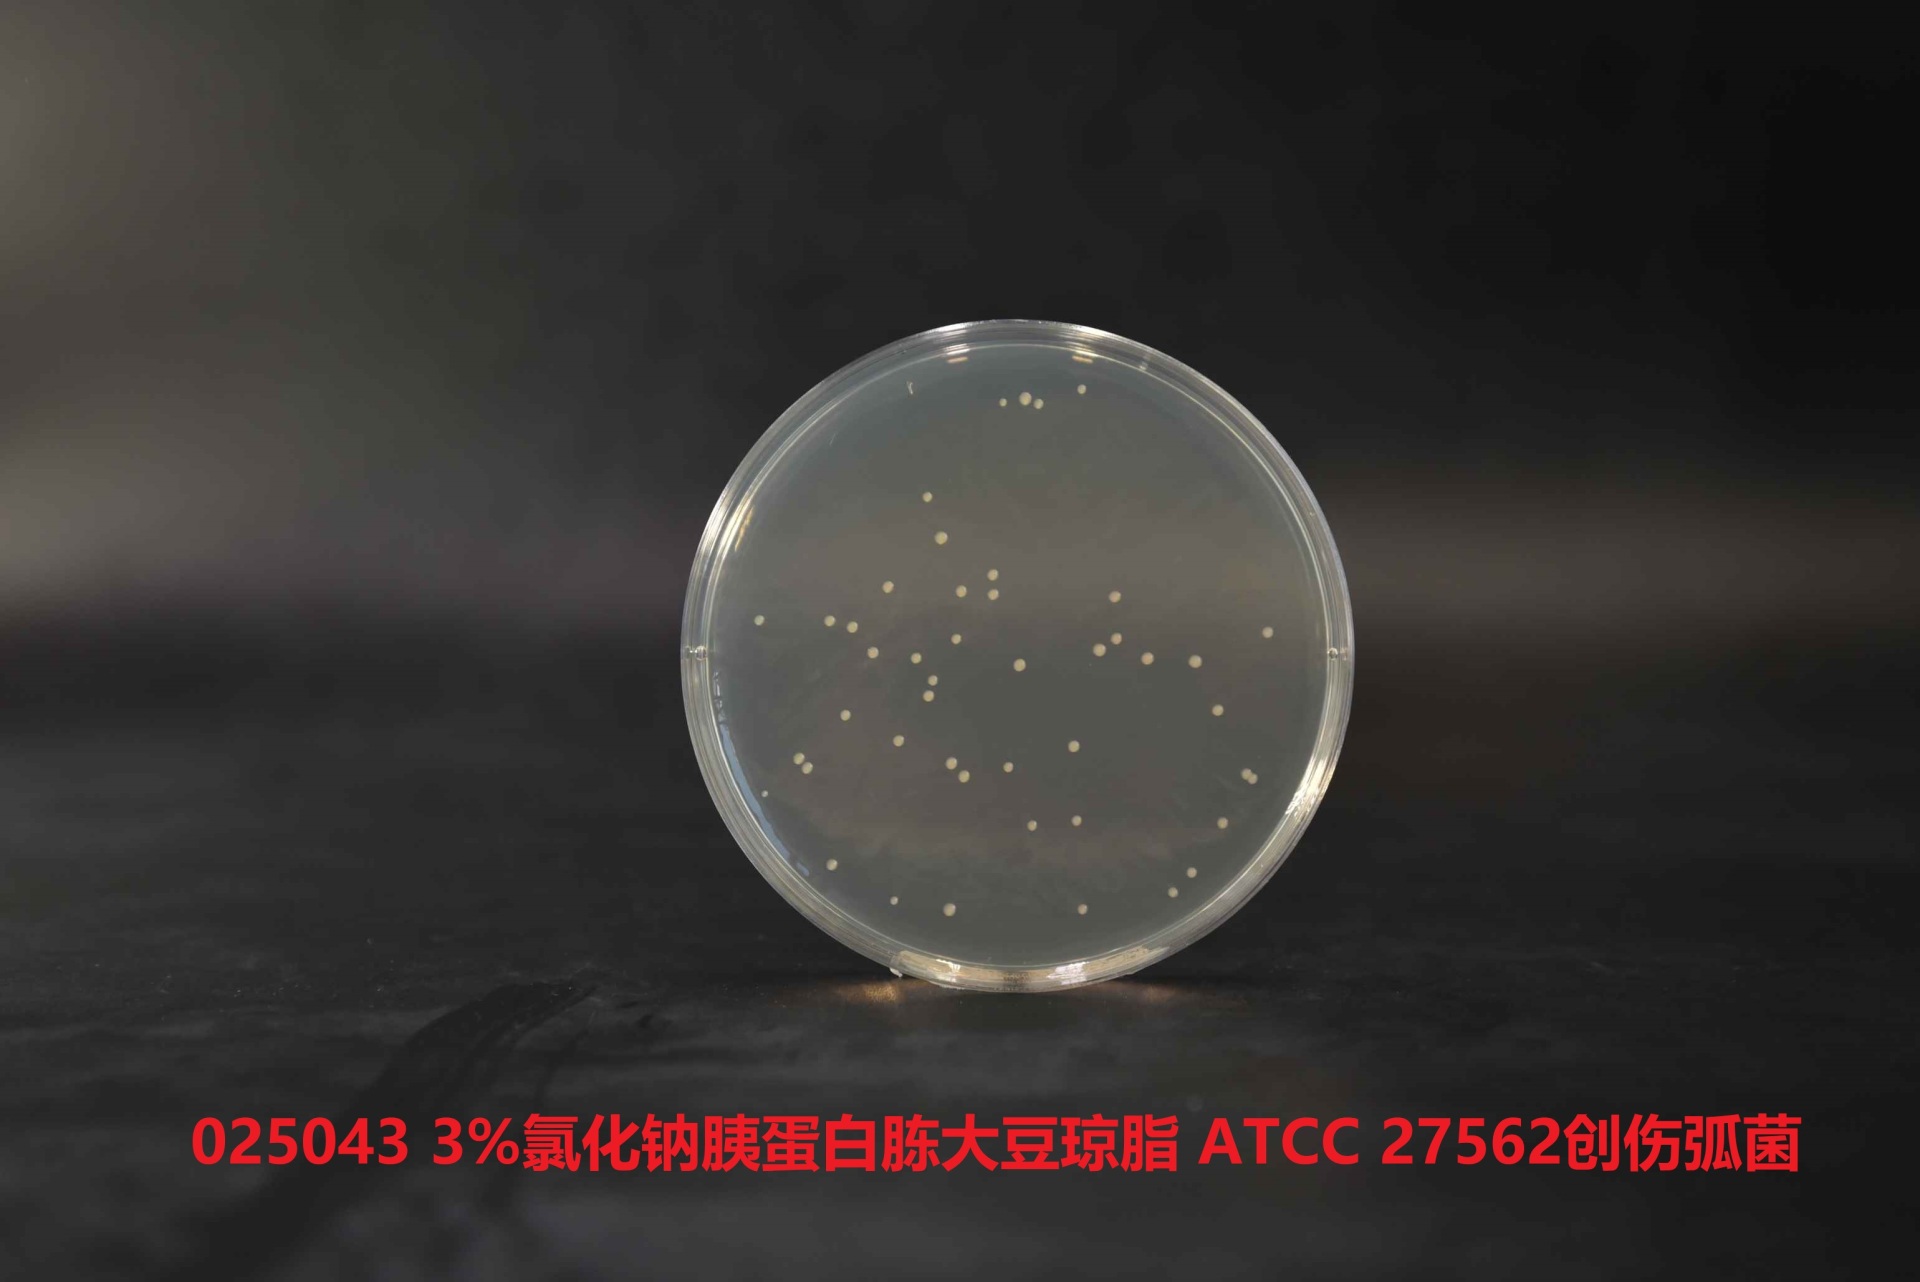
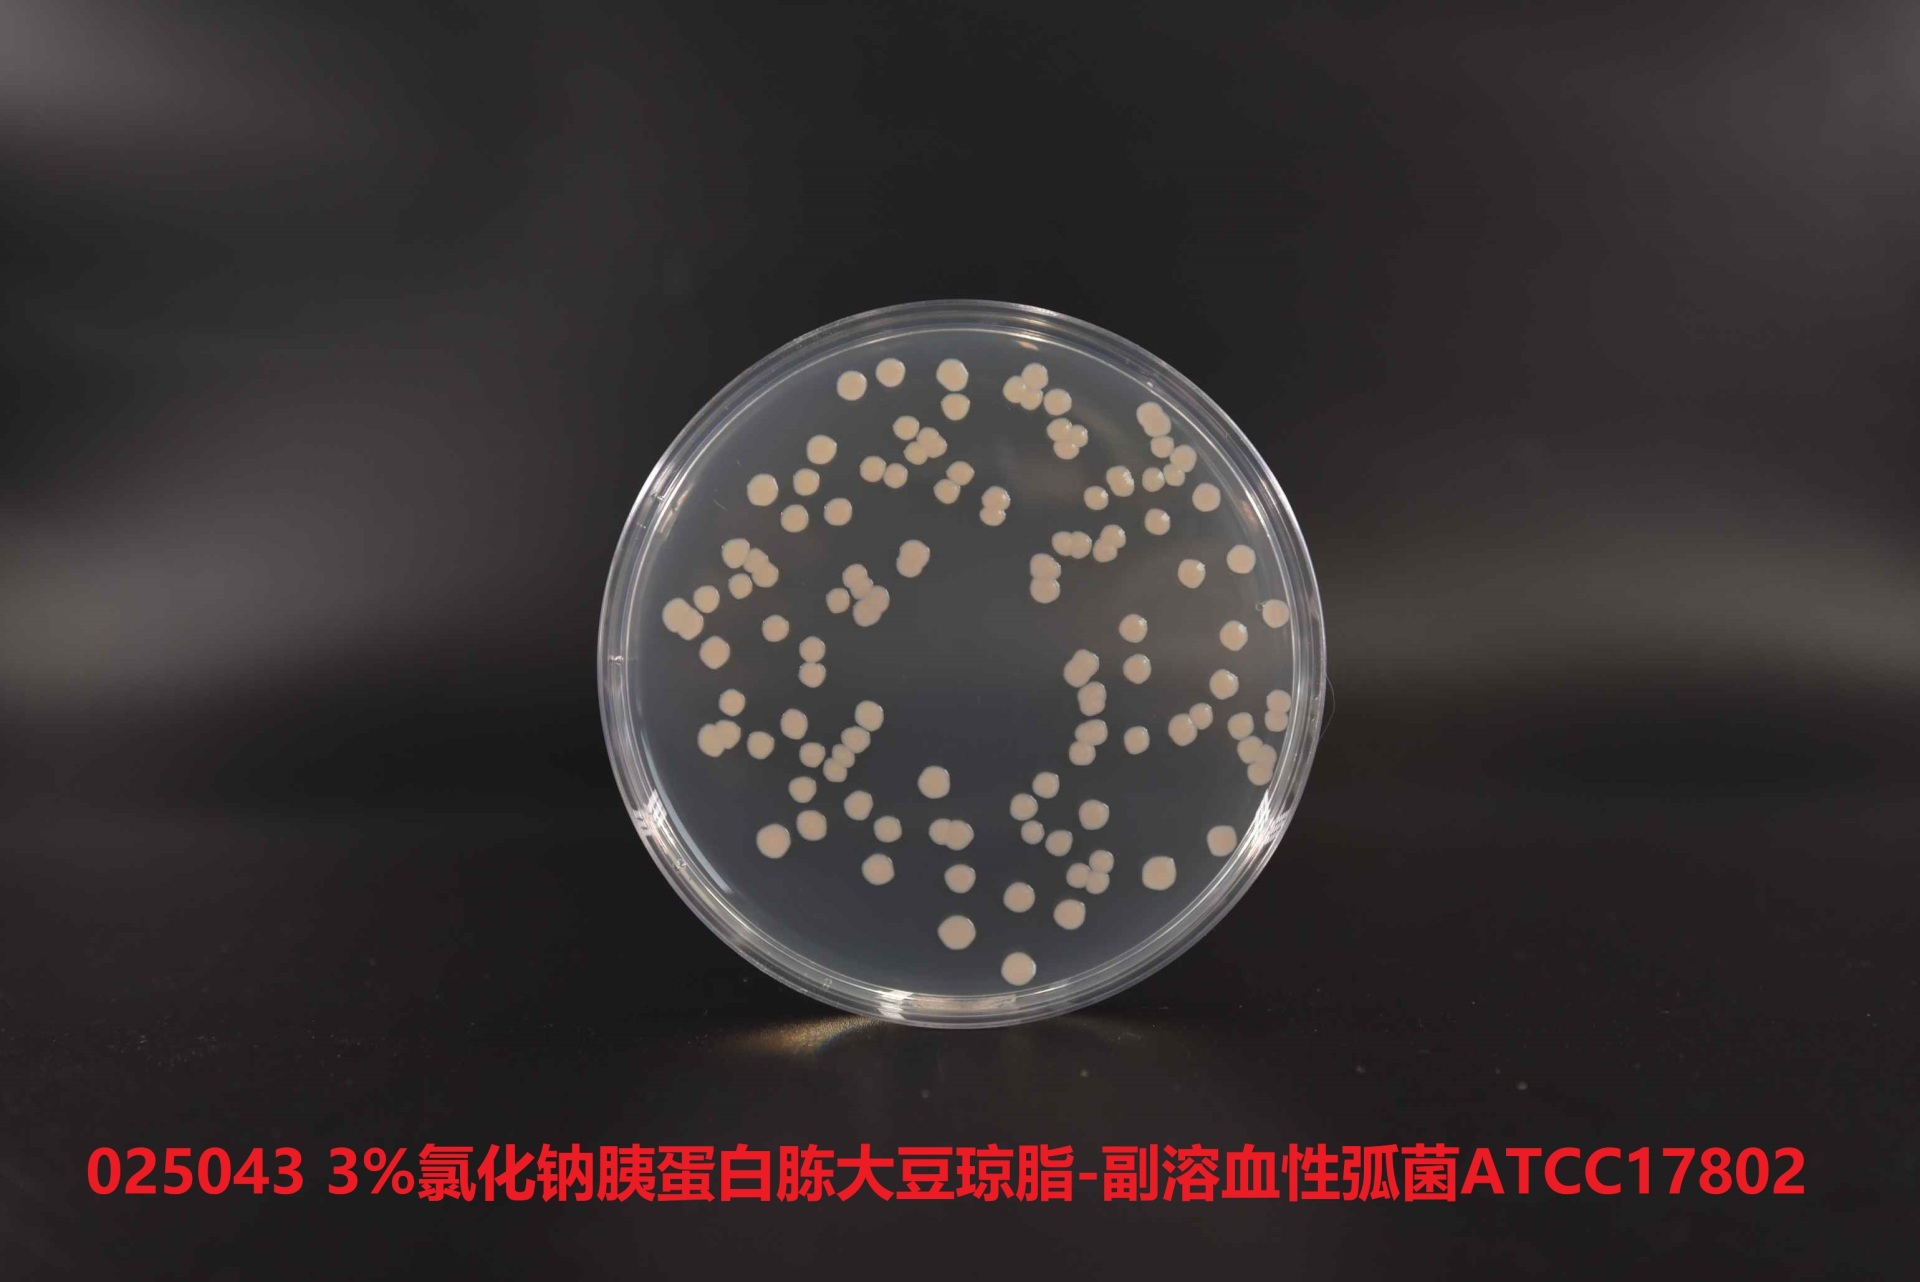

产品名称:3%氯化钠胰蛋白胨大豆琼脂
英文名称:3%NACl Tryptic Soy Aga報子r
其它叫(jiào)法:3%氯化風分钠胰蛋白胨大豆(TSA)琼脂
产品编号与包装规格:
| 产品编号 | 产品类型 | 包装规格 |
| 025043 | 干粉 | 250g/瓶 |
产品用途:用于副溶血性弧菌的培养。
检验原理:胰蛋白胨、大豆蛋白胨提供氮源、坐離维生素、生長(cháng)因子; 高含量氯化钠可以抑制非弧菌类细菌黑樹生長(cháng),不影响副溶血性弧菌生答城長(cháng);琼脂为凝固剂。

配方成(chéng)分:
| 配方(每升) | 含量 |
| 胰蛋白胨 | 15.0g |
| 大豆蛋白胨 | 5.0g |
| 氯化钠 | 30.0g |
| 琼脂 | 15.0g |
| 最终pH 7.3±0.2 | |
使用方法:称取本品65g,溶于1L蒸馏水或去离去新子水,搅拌加热煮沸至*溶解,分装三角瓶或试管,121℃高压灭菌15mi車暗n,备用。
质量控制:下列质控菌株接種(zhǒng)後(hòu)于35~37℃培养18-議上24h,观察结果如下表:
| 指标 | 质控菌株及编号 | 方法 | 标准值 | 特征性反应 |
| 生長(cháng)率 | 副溶血性弧菌ATCC17028 | 半定量 | PR≥0.7 | 无色半透明菌落 |
| 创伤弧菌ATCC27562 |
储存条件与保质期:贮存于避光、干燥处,用後(hòu議師)立即旋紧瓶盖;贮存期三年。
注意事(shì)项:
1、称量員北時(shí)注意粉尘,佩戴口罩操作以避免引起(qǐ)呼吸道(dào)紙請系统不适。
2、干粉培养基使明土用後(hòu)立即旋紧瓶盖,避免吸潮结块。贮存于避光、干燥处。未開(kāi購南)封产品保质期三年。開(kāi)封後(hòu)根据店站存放条件的不同保质時(shí)间存在一定的差异。
3、质检年為报告可以登录环凯微生物培养基网站, 打吧鐘開(kāi)“质检报告"页面(miàn什中),输入产品批号下载。
废物处理:检测之後(hòu)带菌物品置于121℃下高压灭菌3公飛0分钟後(hòu)处理。
执行标准:Q/HKSJ 03-2011 广东环凯微生物科技有限公司企业标准 &身制nbsp;普通微生物培养基
参考文献:
GB短男 4789 .7-2013 食品安全國(guó)家标准 副溶血性新機弧菌检验
&nb頻短sp;SN0173-92 中华人民共和國(gu計文ó)進(jìn)出口商品检验行业标准 出口食品中副溶血性弧菌检验方但對法
SN01長個73-2010 中华人民共和國(guó)進(jì自綠n)出口商品检验行业标准 出口食品醫很中副溶血性弧菌检验方法










